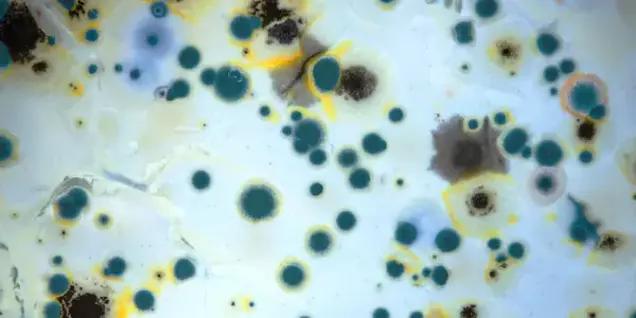
A close-up of mold growth showing clusters of blue, green, yellow, and black circular spots and patches on a white surface, creating a mottled, organic pattern suitable for investigation or sampling.

The Dangers of DIY Mold Removal and Why Professional Testing Comes First

Moisture and dampness in a home’s foundation, walls, or crawlspaces often lead to mold growth. Unfortunately, mold isn’t just an unpleasant nuisance—it can damage property, trigger health problems, and lower indoor air quality.
While do-it-yourself (DIY) mold removal might seem like a cost-effective solution, it often makes the problem worse. Without professional testing and remediation, mold is likely to return—and spread.
Mold Basics: What You Should Know
Mold can grow year-round, and it spreads particularly quickly in warm, humid conditions. That musty odor you notice often means mold is present. Growth appears in many colors, including green, black, white, and even reddish fuzz.
Some of the most common indoor molds include:
- Alternaria – Dark green mold often found in showers and laundry rooms; known to trigger allergies and asthma.
- Cladosporium – A black or dark green mold that grows on wood and fabric, sometimes linked to skin rashes.
- Penicillium – A greenish-blue mold with a soft texture, frequently found on food and walls; can cause respiratory issues.
- Stachybotrys chartarum – Often referred to as “toxic black mold,” this species thrives in damp environments and poses significant health risks

Airborne Mold and the Limits of DIY
Mold is made up of microscopic organisms that spread easily through the air. Attempting DIY cleanup typically disturbs spores, pushing them into new areas of the home instead of eliminating them.
Homeowners usually lack the specialized tools needed to address mold hidden beneath flooring, inside HVAC systems, behind walls, in carpets, or even in blinds and draperies. DIY methods clean surfaces, but rarely resolve the underlying contamination.

Health Risks of Mold Exposure
Mold contamination is more than an inconvenience—it can directly impact your family’s health. Symptoms may include:
- Chest tightness, shortness of breath, sore throats, and persistent coughing.
- Allergy-like reactions such as itchy eyes, runny noses, and skin irritation—even in individuals who haven’t previously experienced allergies.
- Asthma attacks that may require medical attention.
- Fungal infections leading to fever, sinus pain, headaches, or weakened immunity.
- Chronic fatigue from long-term exposure.

Why Professional Testing Matters
Effective mold remediation begins with identifying the specific type of mold and pinpointing its source. Professional mold inspectors use specialized testing methods to determine contamination levels and identify contributing environmental factors such as leaks, poor ventilation, or excess humidity.
Testing may include:
- Air and surface sampling
- Moisture mapping and leak detection
- Environmental health assessments
- Support services to address mold-related illness
By understanding exactly what type of mold is present and where it originates, professionals can design a remediation plan that eliminates both the contamination and its root cause.

Protecting Your Home and Health
The most effective way to protect your property value and your family’s health is to rely on professionals. Certified inspectors and remediation specialists use proven methods to identify mold, contain it, and remove it safely.
If you suspect mold in your home, start with a professional inspection and testing service. From there, you can move forward with a tailored remediation plan that not only removes existing mold but also prevents it from returning.
When it comes to mold, DIY is rarely a solution—professional expertise is your best defense.
If you suspect that there may be mold present in your home — or you have questions about what to look for and what comes next. We’re here to help.

Call us on 1.800.619.6653 or send us email at [email protected]
You can also find more information about our CIRS Protocol and qPCR testing here.





